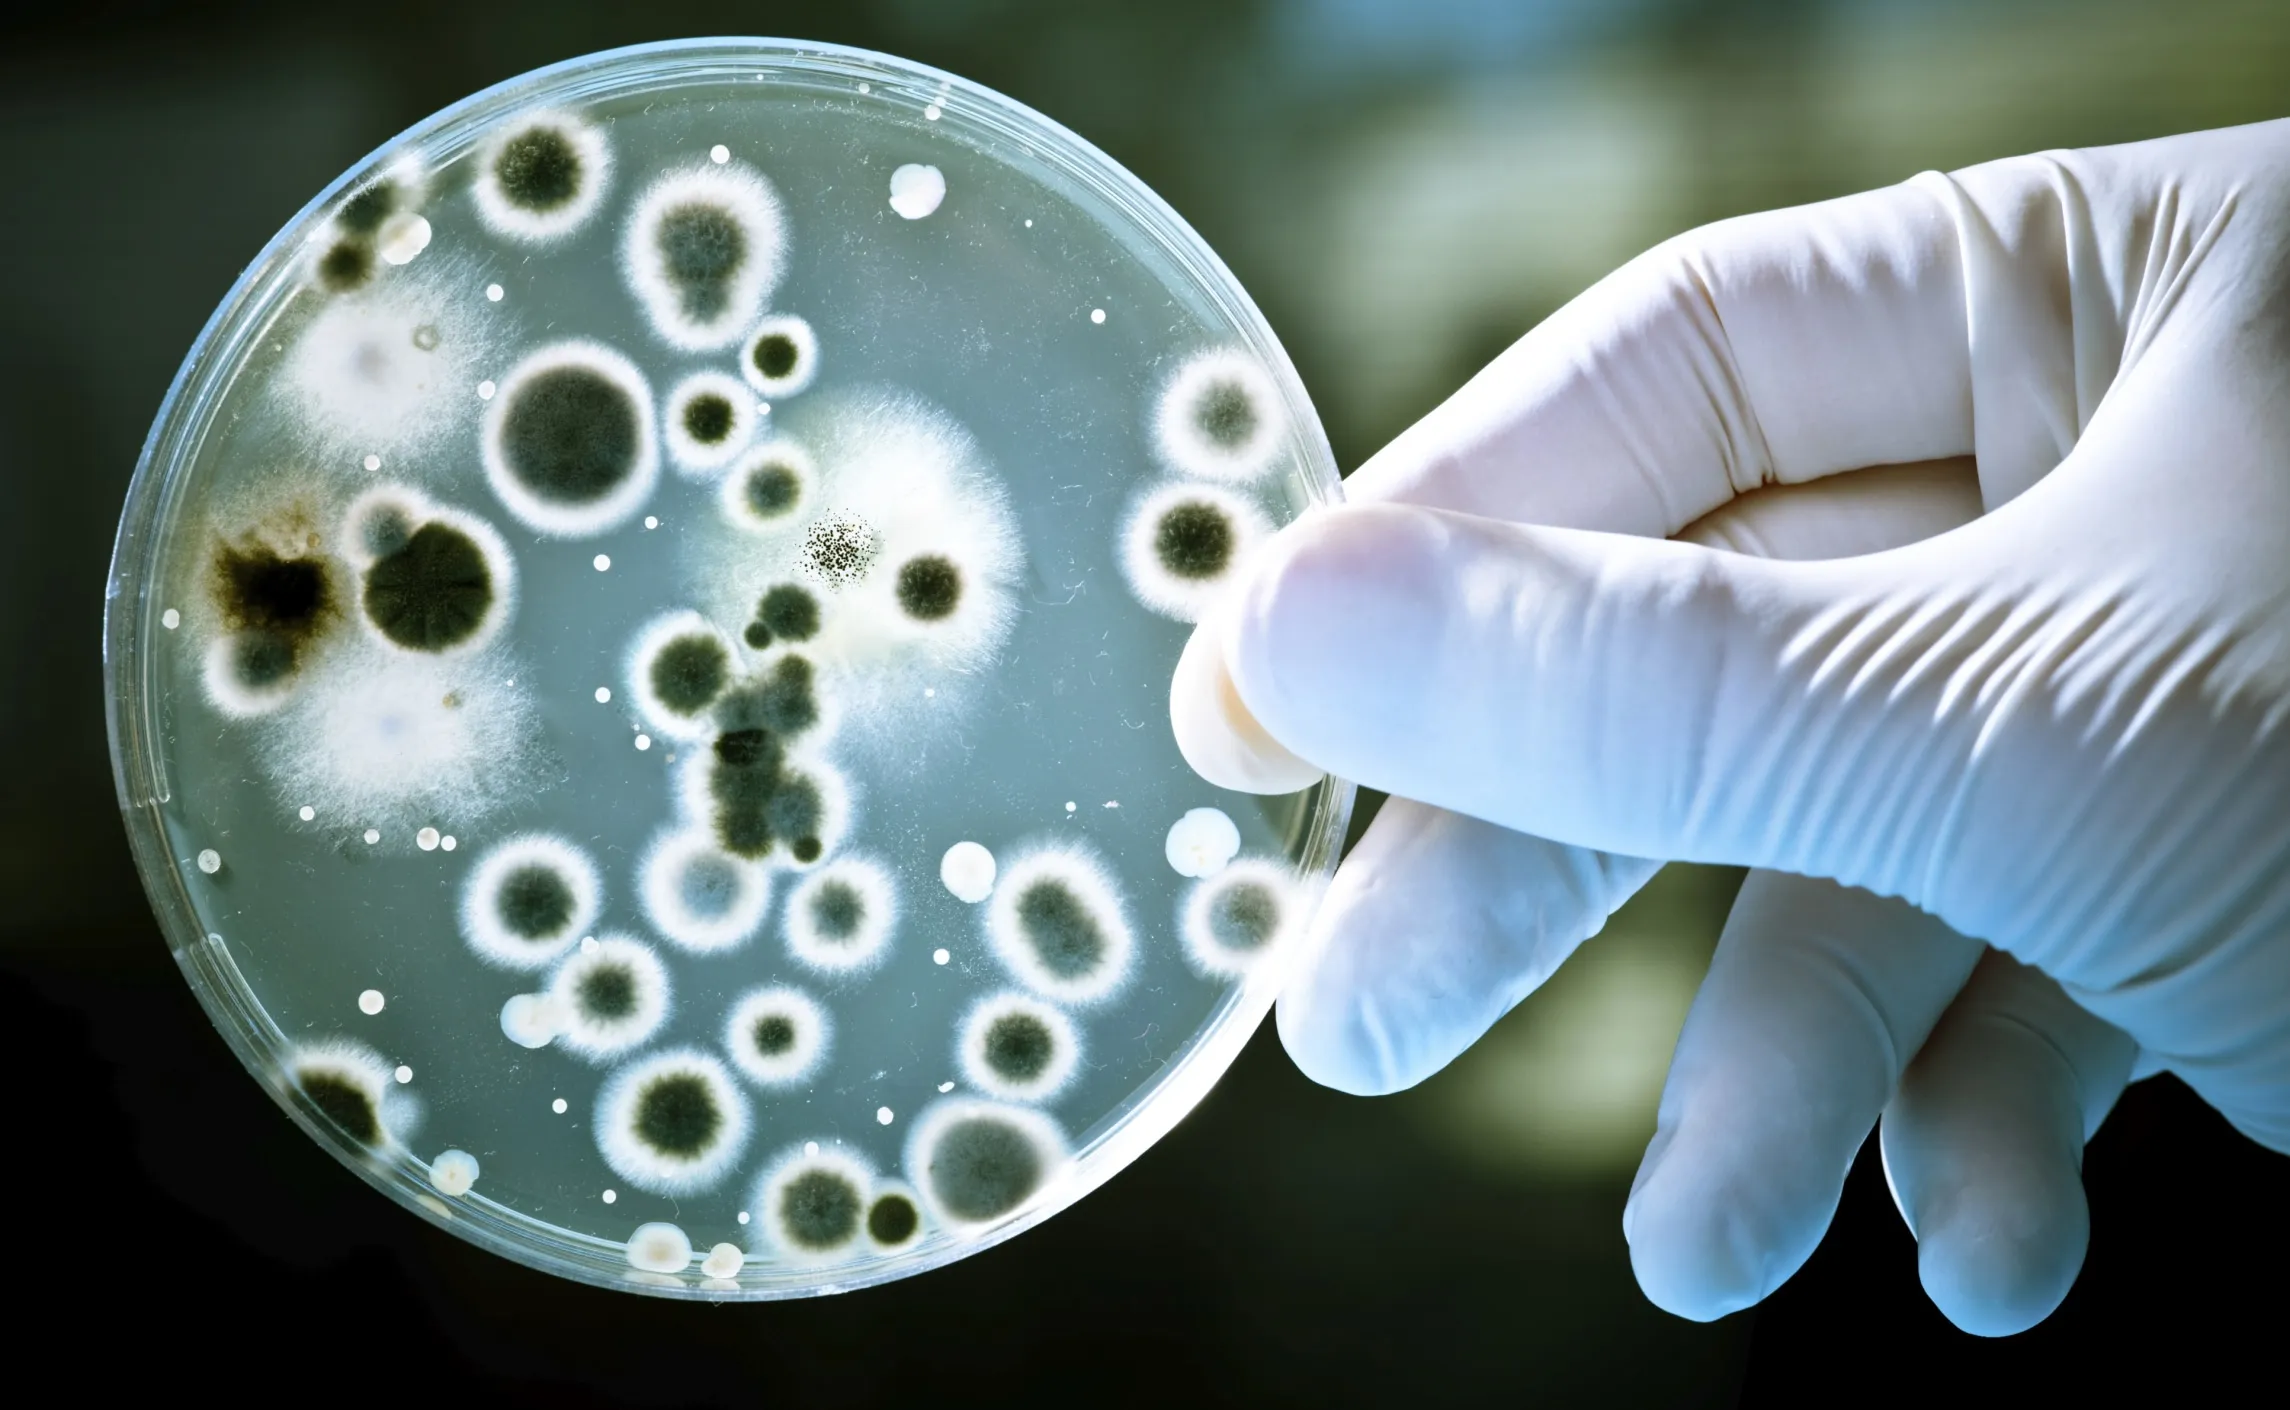
Bacteria Use Electronic Messaging

Did you ever think about how bacteria life could look like? Thanks to modern technologies, we are now able to research bacteria social behavior, which seems quite familiar. Scientists found out that bacteria use a universal language that helps to invite foreign workers to help build complex multicultural cities in order to inhabit the planet together.
Their motto is "strong in solidarity". As one single bacterium is quite helpless and wouldn't be able to survive for long, a large group of bacteria is capable of rather complex and more sustainable actions.
The building site for a bacteria city consists of "biofilm". Growing the city works in a quite unexpected way. The biofilm expands itself in two hour circles, during which it grows and pauses and repeats. These breaks are crucial in the establishment of the site, as nourishment is just able to reach the cells living in the heart of the city, while the growing process is stopped. In this time the outer areas have to suffer in order to reinforce the inner part, a beneficial act to the whole community.
Commonly known, bacteria structure their behavior through a network of chemicals called quorum sensing. Recently though, scientists noticed that bacteria use another language, a universal one, to connect via high distance and cross cultural. Surprisingly, it's a electric messaging system. Comparable to how neurons establish our thoughts. As soon as one bacterium opens its own channel, ions are able to stream through and trigger the nearby located channels to open likewise, creating a electrical pulse that carries on via the whole bacteria stem.
Jacqueline Humphries from the University of California, San Diego, says: “Maybe they just send out these ads, get whom they can, and then work out how to live together". What this example once again proves is that it's all about communicating and working together, because that is what nature does best.
source: The Atlantic. Image: HDWLP
Comments (0)
Share your thoughts and join the technology debate!
No comments yet
Be the first to share your thoughts!